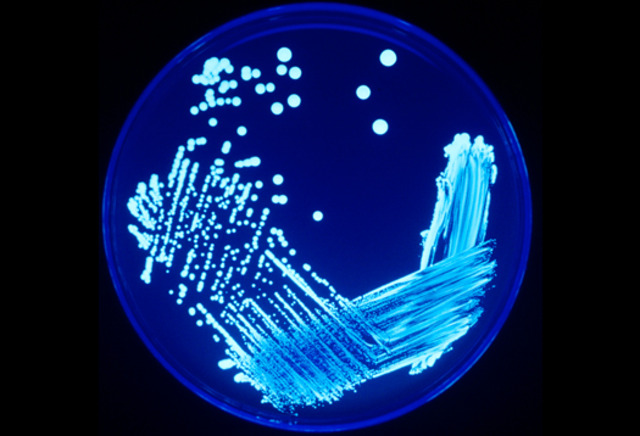
Legionnaire’s disease workcited

-
-
-
The EPA stand for Environmental Protection Agency it is a federal government agency. It helps with health and environment. It began on 2, 1970 the EPA is not like a cabinet. The agency has around 17,000 people employed. Before 1970 a factory could have black clouds of waste come out or they could dump their toxic waste into a nearby lake. Because there was no EPA, no Clean Air Act, and no Clean Water Act it was perfectly legal. In December 1970 congress created the EPA for this issue.
-
http://en.wikipedia.org/wiki/Kent_State_shootings
http://en.wikipedia.org/wiki/Cambodian_Campaign
http://www.google.com/imgres?q=kent+state+shooting&um=1&hl=en&sa=N&biw=1280&bih=905&tbm=isch&tbnid=wSq7WkONn5inZM:&imgrefurl=http://politics.gather.com/viewArticle.action%3FarticleId%3D281474978213501&docid -
Vietnam during the middle of the 1970’s. It was President Nixon who decided to invade. Other students have been shot just by walking by. The response to it nationally was shutting down hundreds of Universities, Colleges, and High Schools due to strike of four million students. It had affected the public opinion as a contentious time over the role of United States in the Vietnam War.
-
The Kent State Shootings or know as May 4th massacre. It took place in Kent, Ohio at Kent State University. The shooting of an unarmed guard on Monday, may 4th, 1970. The guard that was spouse to be unarmed had fried 67 rounds over a period of 13seconds! Killing four students and harmed nine other. The students were protesting against American Invasion of Cambodia. The American Invasion of Cambodia was a campaign in which a series of military operations happened in east Cambodia and South
-
The Beatles is one of the most popular and admiring musical group. They have become the world’s most popular band. When they came to American they were called the British innovation. In 1966 they have had a loss of their manager. (Brian Esptein) In 1967 the Beatles suffered with financial aid. In 1970 the Beatles have decided to break up. Paul McCartney wanted to stay in the business so he decided to come out with and album.
-
http://en.wikipedia.org/wiki/The_Beatles'_break-up
http://www.google.com/imgres?q=the+beatles&um=1&hl=en&sa=N&biw=1280&bih=905&tbm=isch&tbnid=uP4er_ObFplCUM:&imgrefurl=http://richardskipper.blogspot.com/2011/06/dc-anderson-beatles-judy-stadtand-ore.html&docid=xfgtRG3Z1ipSTM&imgurl=http://3.bp.blogspot.com/-WrlF_bnIfy8/Te4kRrSIlPI/AAAAAAAADwc/4A20Jm1Sm9s/s1600/the-beatles-music- -
putting the ads in magazines, newspapers, and on billboards. Sense the Federal Cigarette Labeling and Advertising Act they HAVE to put a health warning on it.
-
The Public Health Cigarette Smoking Act was one of the major bills in 1964.Cigarette Labeling and Advertising Act passed in 1965, saying that all cigarettes packages in the US are sold with a Health Label. The Act happened in Congress in 1969, but on April 1, 1970 President Nixon finally signed it and became a law. The Adverting of this law didn’t come out till January 2, 1971 because they wanted to still add the commercials in the super bowl. Without the commercials of tobacco on TV they starte
-
http://en.wikipedia.org/wiki/Tobacco_advertising
ttp://en.wikipedia.org/wiki/Public_Health_Cigarette_Smoking_Act
http://www.google.com/imgres?q=%E2%80%A2+Cigarette+ads+are+banned+on+TV&um=1&hl=en&sa=N&biw=1280&bih=905&tbm=isch&tbnid=mmvEmCBMIClflM:&imgrefurl=http://www.admadness.co/2011/01/tobacco-advertising-banned-malta/&docid=p6rXNQNhY1wRoM&imgurl=http://www.admadness.co/wp- -
-
Video Cassette Recording (VCR) was an early domestic video format designed by Philips. It was the first successful home Video recorder system later variants included VCR-LP and Super Video (SVR) formats.
-
http://en.wikipedia.org/wiki/D._B._Cooper
http://www.google.com/imgres?q=DB+Cooper&um=1&hl=en&sa=N&biw=1280&bih=905&tbm=isch&tbnid=eWzRgLeu9g_oTM:&imgrefurl=http://en.wikipedia.org/wiki/D._B._Cooper&docid=wlU0ociQA988uM&imgurl=http://upload.wikimedia.org/wikipedia/commons/thumb/f/f3/DBCooper.jpg/220px-DBCooper.jpg -
D.B. Cooper is used to refer to this unidentified man who hijacked and aircraft. On November 24, 1971 he wanted $200,000 in ransom. The ongoing investigation finally located D.B. Cooper. This case remains unsolved. The suspect purchased the airline ticket under Dan Cooper. No could uncover Cooper’s real identity or where he was. The FBI saw Cooper jump from the aircraft and didn’t find him until 1980 with the ransom money but only some of the money.
-
http://en.wikipedia.org/wiki/M*A*S*H_(TV_series)
iii. http://www.google.com/imgres?q=M*A*S*H+T.V.+Show+Premieres&um=1&hl=en&safe=active&sa=X&rls=com.microsoft:en-us:IE-SearchBox&biw=1366&bih=587&tbm=isch&tbnid=xOsCGyLKVCWxHM:&imgrefurl=http://womc.radio.com/2011/02/28/last-episode-of-mash-anniversary/&docid=Un1kW9Kyb22K-M&imgurl=http://cbswomc.files.wordpress.com/2011/02/mash-tv-show-15_opt.jpg%253Fw%253D385&w=385&h=240&ei=hM15T-CNNYzKiQLC9eGpDg&zoom=1&iact=rc&dur=172&sig=101576431600056998542&p -
- M*A*S*H T.V. is a television series. It’s based on 1968 novel about their army doctors. It’s a series about medical drama and black comedy. M*A*S*H suffered with the first season of being a risk of being it canceled. On September 17, 1972 and ended on February 28, 1983 the most watched television episode in the U.S. breaking over 125 million viewers. Many of the stories in the early season were based on real-life told by MASH surgeons.
-
The Supreme Court put an end to the death penalty for killers who committed their crimes before they were 18. Those that were being put to death making 16 and 17 years old were qualified for the execution. The Eight Amendment ban on cruel and unusual punishment. They drew the line at age 18 for many purposes between childhood and adulthood. The court said the punishment was unfair because the blacks were more likely to be executed more than whites.
-
http://www.npr.org/templates/story/story.php?storyId=4518051
i. http://www.google.com/imgres?q=death+penalty&um=1&hl=en&safe=active&rls=com.microsoft:en-us:IE-SearchBox&biw=1093&bih=470&tbm=isch&tbnid=CYz6bGTK-gtsIM:&imgrefurl=http://www.inquisitr.com/19512/death-penalty-on-the-way-out-in-the-united-statesdue-to-cost/&docid=MH1OMc274-5RGM&imgurl=http://www.inquisitr.com/wp-content/death-penalty.jpg&w=504&h=387&ei=Pvt9T_CKHYOniQKSuKCiDg&zoom=1&iact=rc&dur=157&sig=109349479409339780097&page=1&tbn -
Apollo 17 was the eleventh and final manned mission. It launched at 12:33am on December 7, 1972. It returned to earth on Decmeber 19 after 12-day mission.
-
http://en.wikipedia.org/wiki/Apollo_17
http://www.google.com/imgres?q=the+last+man+on+the+moon+1972&um=1&hl=en&safe=active&sa=N&biw=1093&bih=470&tbm=isch&tbnid=eQ43vRWJ1AiOMM:&imgrefurl=http://www.armaghplanet.com/blog/2012space-odyssey.html&docid=Yk3UE6skWjxGRM&imgurl=http://www.armaghplanet.com/blog/wp-content/uploads/2012/01/Image-of-last-man-on-the-moon.jpg&w=580&h=581&ei=Mfl9T-eeJ6euiQL7n9iIDg&zoom=1&iact=hc&vpx=827&vpy=2&dur=1125&hovh=225&hovw=224&tx=129&ty=48&sig=109349479409339780097 -
-
The War Act passed in 1973 it is a Federal law intended to check the power of the President without the approval by Congress. This proves the President can send the U.S Armed Forces into action but congress has to also approve it. The President can notify Congress within 48 hours with the issues, but the President can send the U.S. armed forces, but they can only stay there for 60 days. Then the U.S. armed forces would have to come back unless congress tells them differently.
-
Abortions in the United States have been legal in every state since 1973. The Supreme Court had a case Roe vs. Wade. Roe, the legality of abortion was decided by the states. It was illegal in 30 states and under certain cases in 20 states. Roe established “the right of personal privacy.” They created a new standard specifically to balance the state’s and the woman’s interests in the case of abortion.
-
http://en.wikipedia.org/wiki/Abortion_in_the_United_States
http://www.google.com/imgres?q=Abortion+Legalized+1973&um=1&hl=en&biw=1280&bih=905&tbm=isch&tbnid=J21nDJGm7yA_5M:&imgrefurl=http://www.religionlink.com/tip_110119.php&docid=wjUo7qhkV9EUbM&imgurl=http://www.religionlink.com/clipart/abortion%2520sign.jpg&w=800&h=518&ei=33F_T-qkDujC2wW_ldH9Bg&zoom=1&iact=rc&dur=495&sig=100263530963709209647&page=1&tbnh=144&tbnw=223&start=0&ndsp=20&ved=1t:429,r:14,s:0,i:97&tx=121&ty=69 -
-
The Endangered Species Act happened on December 28, 1973. It expressed a concern that many of our nation’s native plants and animals were in danger of becoming extinct. The purpose of the ESA is to protect species that are endangered.
-
-
a presidential pardon by President Bill Clinton in his last official act before leaving office.
-
Patricia Carempbell Hearst was known as a American newspaper, actress, kidnap victim, and convicted bank robber. Her kidnapping case is considered an example of Stockholm syndrome. It means that she was kidnapped then she started liking the guy that she was kidnapped by. In the by kidnapping the Symbioses Liberation Army, she joined her captors in furthering their cause. After the bank robbery with the SLA members, she was imprisoned for almost two years before her sentence. She was later grante
-
The National Maximum Speed Law in the United States happened on May 31, 1974. The Emergency Highway Energy Conservation Act changed the speed limits 55 miles per hour. It was a Safety benefit because people would crash all the time until the change the speed limits. It decreased in car crashes per year.
-
-
. Over thirty years ago, Little League Baseball was changed forever - a change that eventually would allow millions of girls to participate in the world's largest organized youth sports program New Jersey Civil Rights Division on Nov. 7, 1973, was later upheld in the Superior Court, leading to Little League Baseball's access of girls into its programs. Until then, Little League regulations had prohibited girls from participating, and the change led to greater opportunities, such as those for the
-
-
10 girls who played on teams that have reached the Little League Baseball World Series. So, in 1974, Little League Softball for girls was created, and the baseball rules and regulations were made non-gender specific. In 1974, nearly 30,000 girls signed up for the softball program. One in 57 Little Leaguers that year was a girl. The move came amid lively debates on women's rights. It was three years after President Nixon signed Title IX into law.
-
Microsoft Corporation is an American headquartered in Redmond, Washington that develops, licenses and supports a wide range of products. It was made on April 4, 1975 to develop and sell the home computer operation system.
-
-
o Ashe Makes History by being the first black man to win a Wimbledon. Tennis player Arthur Ashe has become the first black man to win the Wimbledon singles’ championship. Ashe beat defending champion Jimmy Connors three sets to court. Speaking after the game Ashe always wanted to win and he was very confident in himself that he would win. Ashe won his first service game to love and quickly broke his opponent serve in the first set.
-
http://news.bbc.co.uk/onthisday/hi/dates/stories/july/5/newsid_2798000/2798971.stm
http://www.google.com/imgres?q=Arthur+Ashe+First+Black+Man+to+Win+Wimbledon&um=1&hl=en&sa=N&biw=1280&bih=905&tbm=isch&tbnid=V467lrCbUpgPGM:&imgrefurl=http://vasishta.wordpress.com/2008/07/28/arthur-ashe/&docid=EJgv6W1cCTNaHM&imgurl=http://vasishta.files.wordpress.com/2008/07/arthur-ashe-and-trophy.jpg&w=840&h=1151&ei=HvqET_bQAsSA2gWqvZ3pCA&zoom=1&iact=hc&vpx=311&vpy=199&dur=4664&hovh=263&hovw=192&tx=120&ty=128 -
-
On October 1, 1936 by Francisco Franco and the National Defense Committee formed a government. The government otherwise known as regime goes the victory in the Spanish Civil War. Franco’s rebellion had been backed from aboard by Fascist Italy and Nazi Germany while the Second Spanish Republic was backed by Stalinist Soviet Union and Mexico. At the end of the Spanish Civil War, according to the calculations of the regime, there were more than 270,000 men and women held in the regime's prisons and
-
women held in the regime's prisons and some 500,000 fled into exile. With the death of Franco on 20 November 1975, Juan Carlos became the King Of the Spain. He immediately began the process of democracy. Ending a constitutional monarchy articulated by a parliamentary democracy.
-
-
Red Hair die Number 2 was banned because it is dark red to purple one used as a food dye and to color was cosmetics but sense 1976 it has been banned from the United States by the Food and Drug Administration it was suspected of a type of cancer.
-
-
some mental confusion is present. Although healthy individuals can contract Legionnaire disease, the most common patients are elderly or debilitated individuals or persons whose immunity is suppressed by drugs or disease.
-
• Legionnaire disease is a form of pneumonia caused by the bacillus. The name of the disease derives from a 1976 state convention of the American Legion. The largest known outbreak of Legionnaire disease, confirmed in more than 300 people. Typically, but not uniformly, the first symptoms of Legionnaire disease are general malaise and headache, followed by high fever, often accompanied by chills. Coughing, shortness of breath, like pain, and abdominal distress are common, and occasionally some
-
-
o On October 8, 1975 the president of the United States signed a law directing that women would be admitted to American’s service academies. The military departments concerned shall take such action to make the female individuals be eligible for appointment and admission to the service academy concerned, being in the calendar of 1976.
-
-
.After four years in production, including location shots in Tunisia and Death Valley, California, Star Wars was ready for its release. Though Fox released Star Wars in only 42 theaters, it primed its target audience of science-fiction fans with a massive publicity campaign. By the end of its first week, the film had made $3 million, and by the end of the summer it would rake in some $100 million. Its box-office haul was second only to Gone with the Wind critics and was nominated for 10 Academy.
-
-
The New York City blackout was an electricity blackout that affected most of New York City. The events leading up to the blackout began at 8:37 p.m. on July 13 with a lightning strike at Buchanan South, a substation on the Hudson River tripping two circuit breakers. A second lightning strike caused the loss of two 345 kV transmission lines.
-
http://www.findadeath.com/Deceased/p/Elvis Presley/elvis_presley.htm
http://www.examiner.com/images/blog/wysiwyg/image/lea(1).jpg -
His fiancée,was staying with him, but sleeping in a different room. She was the last person to see him alive. Elvis had probably been dead for two or three hours. He was officially pronounced dead there at 3:30pm. After the announcement was made, 150 fans gathered outside the hospital waiting.. Elvis died of natural causes.According to Dr. Eric Muirhead, a pathologist who helped perform the autopsy, his body contained a total of 14 drugs, including 10 times the normal dosage of codeine and toxic
-
-
On May 17, 1978, Resorts was granted a six-month permit to operate a gambling casino in Atlantic City by the New Jersey control board, and Resorts opened the doors of the first casino on the East Coast. Customers who had traveled from around the country waited in line for hours on the Atlantic City boardwalk to try their hands at the slots and the gaming tables after the governor of New Jersey cut a ribbon to commemorate the opening of this facility.
-
Cambridge University had been working on finding a solution for women with blocked Fallopian tubes. After they found a way to fertilize an egg outside a human body they continued to have problem replacing the fertilized egg back into the women’s uterus. They finally found out a way and Lesley Brown delivered a five pound baby girl.
-
-
-
John Paul II was a Pope of the Catholic Church in 1978. He was one of the longest serving Pope in history and the first non-Italian. He was one of the most traveled world leaders in History visiting 129 countries during his preach.
-
The accident at the Three Mile Island Unit 2 nuclear plant neat Middletown Pennsylvania on March 28, 1979, was the most serious in U.S. commercial nuclear power plant operating history even though it led to no deaths or injuries to plant workers or members of the nearby community. But it brought about sweeping changes involving emergency response planning, reactor operator training, human factors engineering, radiation protection, and many other areas of nuclear power plant operations
-
-
Walkman is a Sony brand trade name originally used for portable audio cassette players, and now used to market Sony’s portable audio and video players as well as a line of former Sony Ericsson mobile phones. The original Walkman introduced a change in music listening habits by allowing people to carry music through lightweight headphones.
-
-
-
Entertainment and Sports Programming Network commonly has known as ESPN an American global cable television network focusing on sports related programming. it launched on September 7, 1979, under the direction of Chet Simmons, the network’s President and CEO.
Looking for a timeline maker?
Create timelines for projects, roadmaps, history, lessons, legal cases, and stories with Timetoast. Timetoast is a timeline maker for work, school, research, and stories.